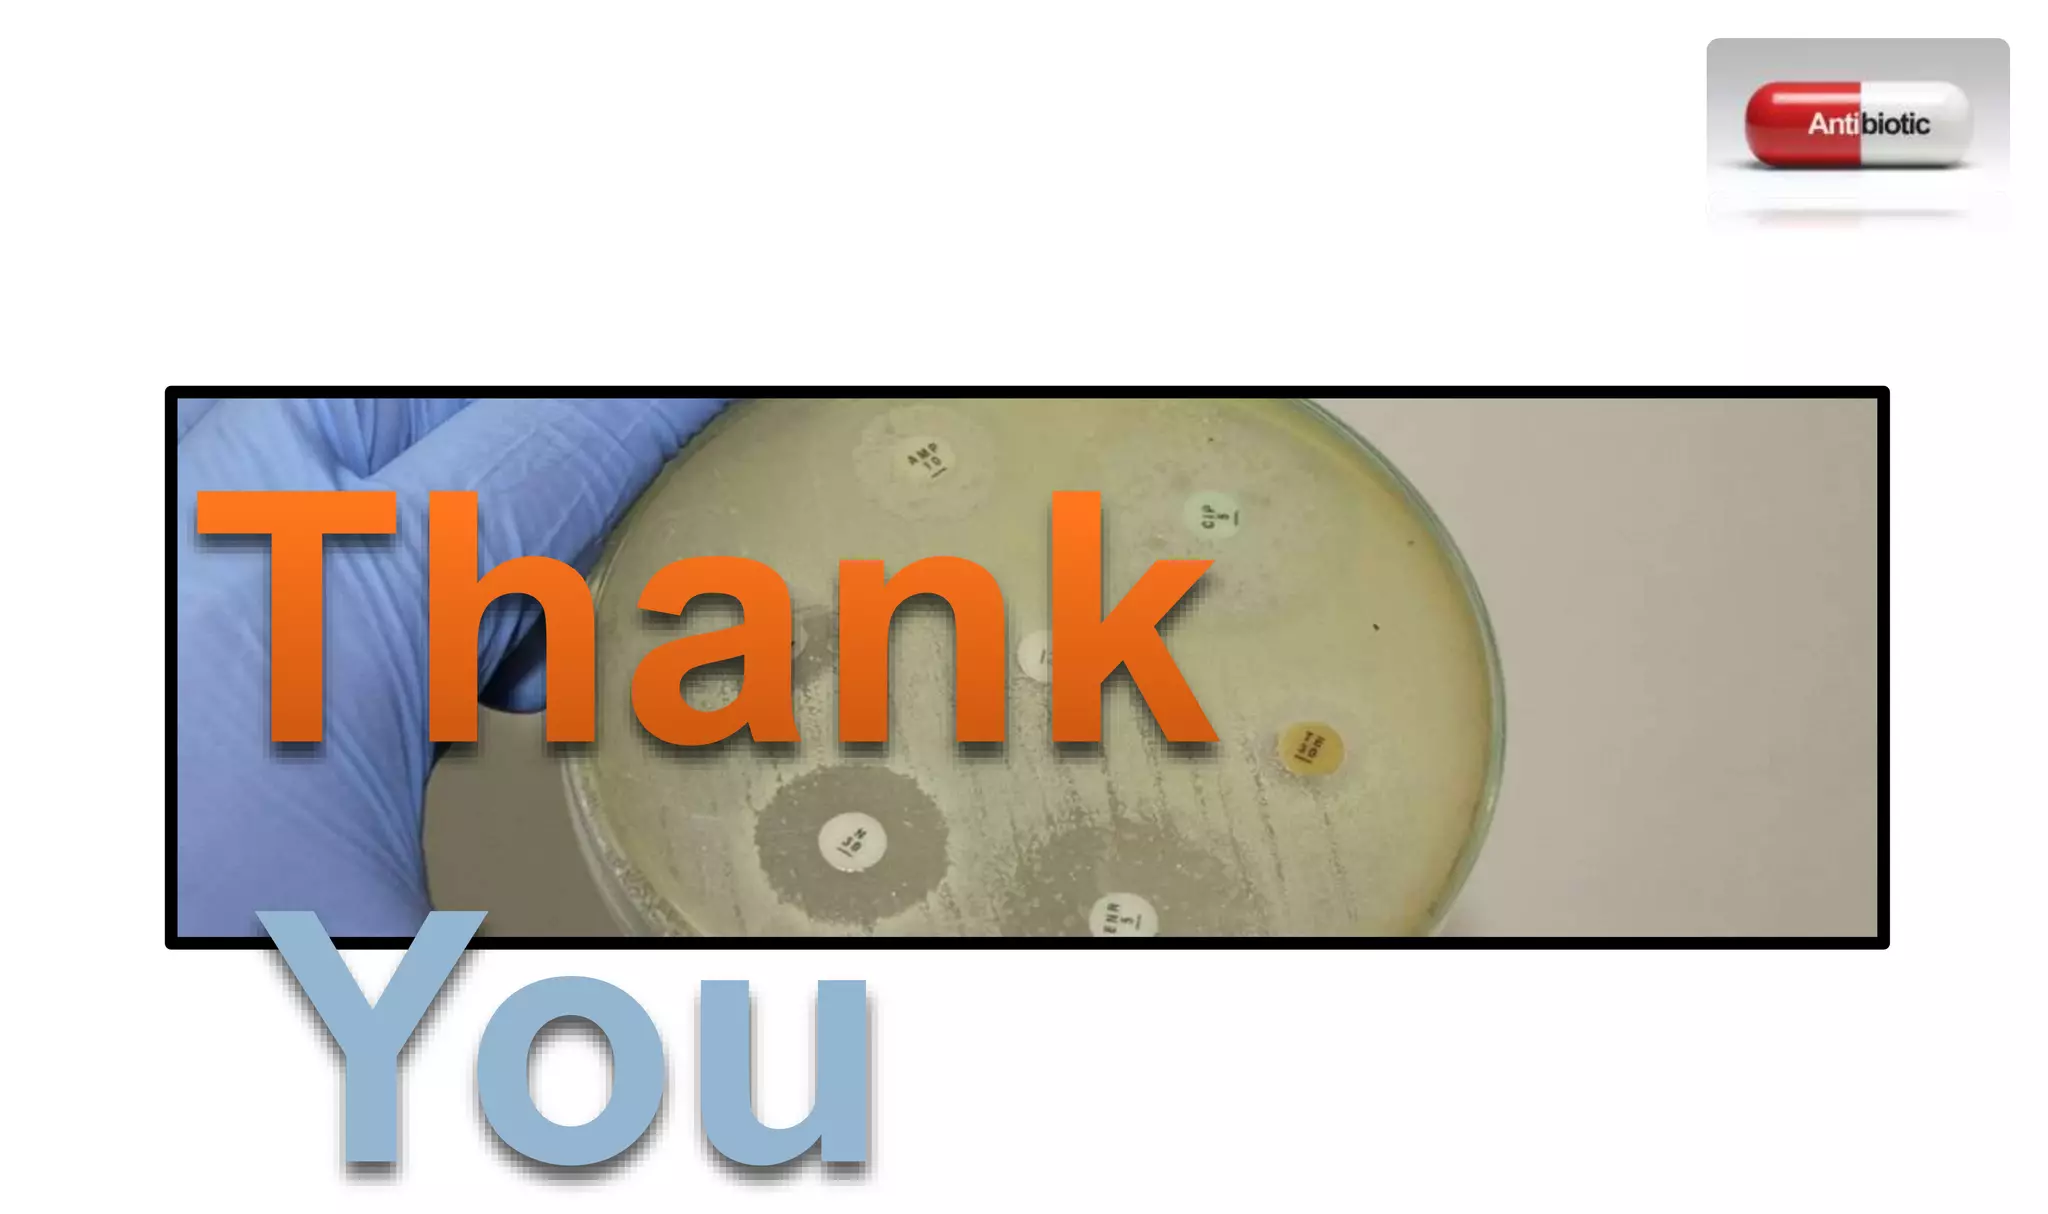
Antibiotic sensitivity testing (AST) | PPTX

Build inspiration with our remarkable architectural antimicrobial sensitivity testing (ast) | pptx collection of countless structural images. spatially documenting photography, images, and pictures. perfect for architectural portfolios and presentations. The antimicrobial sensitivity testing (ast) | pptx collection maintains consistent quality standards across all images. Suitable for various applications including web design, social media, personal projects, and digital content creation All antimicrobial sensitivity testing (ast) | pptx images are available in high resolution with professional-grade quality, optimized for both digital and print applications, and include comprehensive metadata for easy organization and usage. Explore the versatility of our antimicrobial sensitivity testing (ast) | pptx collection for various creative and professional projects. Instant download capabilities enable immediate access to chosen antimicrobial sensitivity testing (ast) | pptx images. Our antimicrobial sensitivity testing (ast) | pptx database continuously expands with fresh, relevant content from skilled photographers. Diverse style options within the antimicrobial sensitivity testing (ast) | pptx collection suit various aesthetic preferences. Regular updates keep the antimicrobial sensitivity testing (ast) | pptx collection current with contemporary trends and styles. Professional licensing options accommodate both commercial and educational usage requirements. Time-saving browsing features help users locate ideal antimicrobial sensitivity testing (ast) | pptx images quickly. Each image in our antimicrobial sensitivity testing (ast) | pptx gallery undergoes rigorous quality assessment before inclusion.